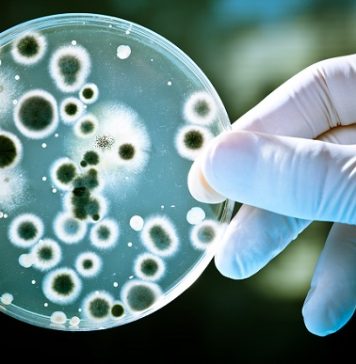
State official Paun: The COVID-19 pandemic has accelerated the pace of innovation, digital transformation

Joia viitoare ar putea fi prima zi de testare a elevilor în școli, a declarat ministrul interimar al Educației, Sorin Cîmpeanu. Potrivit acestuia, s-au solicitat Ministerului Sănătăţii clarificări referitoare la procedura de lucru privind realizarea testelor de salivă pentru elevi și preșcolari. „S-au semnat vineri contractele subsecvente după ce la începutul săptămânii trecute s-au semnat acordurile […]

Proiectul jurnalistic pressonline.ro este un proiect susținut de AGI
- o asociație neguvernamentală, apolitică și non-profit.
- o asociație neguvernamentală, apolitică și non-profit.
Depinde și de tine să susții o presă independentă.